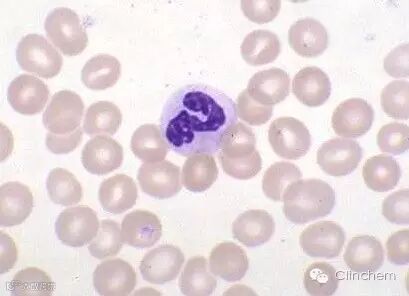
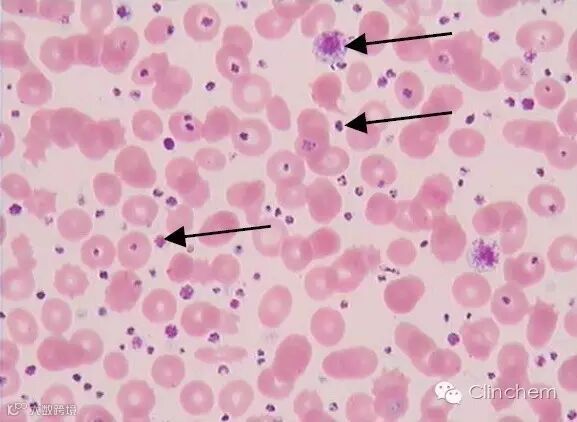
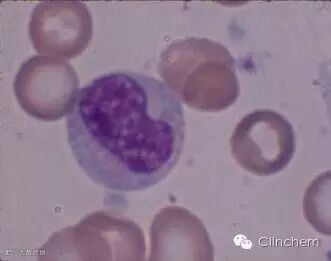
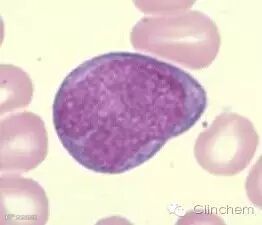

2016年10月15日上午,由顾兵、王宏、高丽、夏文颖、朱立强等代表,在徐州市博顿温德姆酒店金龙厅召开了《形态学检验图谱习题集》编写推进会。


此前,2016年8月,形态学图谱系列丛书包括《临床血液检验图谱与案例》、《临床体液检验图谱与案例》、《临床微生物检验图谱与案例》正式在人民卫生出版社出版。
习题集将收纳以上三个领域的题目,以配合图书供读者学以致用。
目前,习题集已收集检验图谱题目700题,正在审核300题,目前正式面向广大同行征集形态学检验图谱习题500题,机不可失,欢迎各位同行积极投稿!
征题意向:
(1)血液学检验中有关红细胞系统及血小板的相关题目,血液病有关的流式、分子生物学技术检测。
(2)体液学检验有关男性生殖系统的题目。
(3)微生物学检验中有关革兰阴性菌及厌氧菌的题目。
(4)其他与形态学检验相关习题的投稿也欢迎。
欢迎大家积极投稿,要求原创!有意向投稿的可联系本书编写秘书朱立强索要习题样稿。
投稿邮箱:xzzlq1678@163.com 联系人:朱立强18252117062
截止日期:2016年11月20日晚上8点前。
形态学检验图谱习题样稿
一、单选题
出题思路与要求:
涂片需注明来源(外周血、骨髓.......)、放大倍数、染色方法
可以是细胞,也可以是细胞内结构、涂片中的异常现象
可以是单纯图片辨别细胞的题,也可以是结合病例的题
可以是一张图对应几个备选的细胞,也可以是一个细胞对应几个备选的图
1. 外周血片(×1000,瑞-吉染色)中的细胞是( )
A. 早幼粒细胞
B. 中幼粒细胞
C. 晚幼粒细胞
D. 杆状核粒细胞
E. 分叶核粒细胞
【答案】D
【王宏分析】根据细胞大小、核凹陷程度、核分叶情况,应选D。
2.外周血片(×1000,瑞-吉染色)中箭头所指的现象是( )
A. 大血小板
B. 巨血小板
C. 血小板聚集
D. 血小板大小不一
E. 血小板“卫星”现象
【答案】D
【王宏分析】题目要求识别的是“现象”,片中指示了3个血小板,而且很明显3个血小板的大小不一,故选D。
3.骨髓片(×1000,瑞-吉染色)中箭头所指的细胞内结构是( )
B.Auer小体
C.H-J小体
D.Dohle小体
E.Dutcher小体

【答案】B
【王宏分析】题目要求识别的是“结构”。该结构位于粒系细胞中,故排除A(见于骨髓瘤细胞)、C(见于红细胞)和E(见于骨髓瘤细胞)。而Dohle小体常为圆形、梨形或云雾状。
4.下列骨髓片(×1000,瑞-吉染色)中的细胞,为原始粒细胞的是( )
A.
B.
C.
D. 
E.
【答案】A
【王宏分析】前4个细胞均为粒细胞。根据细胞大小、胞浆颗粒、核浆比、核凹陷程度分别为原粒、晚幼粒、中幼粒、早幼粒。最后一个是原单细胞。
二、多选题
1.下列细胞可见于多发性骨髓瘤的是( )
A.
B.
C.
D. 
E. 
【答案】ABCD
【王宏分析】具有代表性的几种骨髓瘤细胞形态:A--Mott细胞(胞浆中含有许多Russell小体。Russell小体在染色中有时会溶解,以致形成空泡);B---大而明显的核仁;C---火焰状细胞(浆细胞内沉积了一些无定形沉淀物,并常染成红色,故名。现已知沉积物也是免疫球蛋白,且多见于IgA型多发性骨髓瘤);D---胞浆中大量紫红色结晶体;E---Dutcher小体(核内包涵体)。


